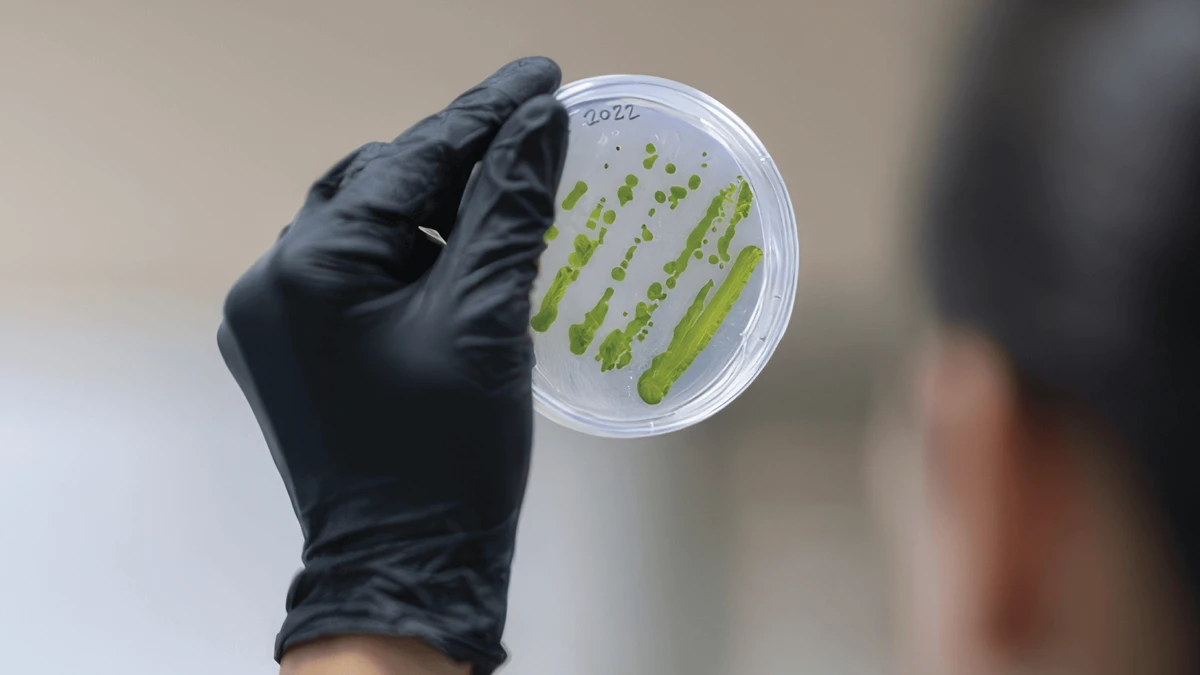

6 novel ways technology is addressing ‘planetary problems’, from making bacon-tasting insects to turning food waste into energy
6 novel ways technology is addressing ‘planetary problems’, from making bacon-tasting insects to turning food waste into energy


Demanding times call for adaptive measures. As the world faces escalating challenges, UBC researchers are thinking outside the box to develop sustainable solutions to global concerns. In doing so, these innovators are drawing upon organic materials that the average person might perceive as unrelated to the issues they’re being applied to. In the following examples, witness creativity in action as experts tackle a diverse range of issues, including diseases, hunger, waste management, energy consumption, environmental degradation, and the climate crisis.
How will we solve our planetary problems? According to these researchers, the answers might lie in unexpected places.

Using plants to prevent microplastic pollution
When you bite into a piece of fruit that isn’t ripe, do you notice your mouth puckering? That’s due to tannins, which are bitter-tasting organic substances found in plants. While they’re used in food and beverages like tea, wine, chocolate, and coffee, as well as dyes and leather, UBC scientists have found a new purpose for these natural materials — to combat the increasingly invasive threat of synthetic pollution.
Microplastics, or plastic particles that are smaller than five millimetres, are accumulating in the earth, water, and air; in plants and animals; and even in our own bodies. That’s because plastics take hundreds, even thousands, of years to decompose.
At UBC’s BioProducts Institute, a research team created a filter using tannic acids from plants, bark, wood, leaves, and sawdust that can remove microplastics from water. In addition to using sawdust from the lumber industry that might otherwise be incinerated or disposed of as waste, the materials are derived from plant sources.
In a study, the researchers found that their method, called bioCap, trapped from about 95 to almost 100 per cent of microplastics released in water from tea bags made of polypropylene. Testing using mice confirmed that this process prevented microplastics from accumulating in organs.
Dr. Orlando Rojas, the scientific director of the BioProducts Institute, explains that microplastics can be difficult to capture because of their varying shapes, sizes, and electrical charges.
“There are microfibres from clothing, microbeads from cleansers and soaps, and foams and pellets from utensils, containers, and packaging,” he says. “By taking advantage of the different molecular interactions around tannic acids, our bioCap solution was able to remove virtually all of these different microplastic types.”
This method could be applied to everything from small-scale usage, such as water filters in households, to large projects, such as wastewater-treatment plants.
To learn more about the urgent need to address microplastics and the surprising extent of the issue, consider watching the 2024 documentary Plastic People: The Hidden Crisis of Microplastics featuring science journalist, author, and UBC alum Ziya Tong (BA’94).
Fruitful energy of the future
Do you notice how much food you throw out each week? How about each month? Or each year?
Food waste is a significant contributor to landfills and greenhouse gas emissions. The United Nations reports that about 13 per cent of food is lost in the transition from harvest to retail while households, food service, and retail discard an estimated 17 per cent of global food production. In Canada alone, approximately $50 billion worth of food ends up in landfills or composts each year, according to the National Zero Waste Council.
Initiatives to reduce food loss, such as voluntary efforts by retailers or food-scrap collection, are underway. But could food waste become a source of energy?
That’s what UBC Okanagan engineers have been investigating. UBCO researcher Dr. Hirra Zafar (PhD’23) zeroed in on what’s bountiful in the Okanagan: fruit.
In Zafar’s research, microbial fuel cells were used to transform fruit waste into electrical energy. These cells use microbes that consume organic matter and subsequently release electrons and protons. As the combination of these electrons with protons and oxygen produces water, this process also generates bioelectricity.
The researchers found that separating and grinding up food waste improved the process efficiency. Zafar explained that they also discovered that microbial fuel cells produce different results based upon what fruit is used due to varying biochemical characteristics.
“Microbial fuel cells are really at their developmental stage and they have so much potential,” Zafar says. “At this point, the voltage remains low, but I am excited to investigate how to improve their power output and apply these practices on a commercial scale.”
Other UBC researchers have also been exploring the use of microbial fuel cells. Engineering design team UBC Rocket, for instance, has investigated if bacteria-based batteries, using sewage, could become a sustainable source of energy, water, and rocket fuel in space. In 2022, they examined how microgravity affects microbial fuel cells, and this year, they will test how hypergravity affects these fuel cells.
Light up your life — with bacteria
In the quest to reduce electricity consumption, our interiors could one day be illuminated with light from living organisms, believe it or not.
This vision could become a reality thanks to undergraduate researchers from UBC Okanagan. Guided by principal investigators Dr. Isaac Li, now an associate professor of biochemistry and molecular biology, and Dr. Mitra Tabatabaee (PhD’22), now an assistant professor at the University of the Fraser Valley, a team of students created a light bulb that doesn’t require electricity. Instead, this light source harnesses solar power and bioluminescence — a natural process that enables certain organisms to glow — to produce light from organic material.
The Life Bulb emits light from genetically modified bioluminescent bacteria. In addition to being powered by sunlight, it can also convert greenhouse gases into oxygen. An additional benefit is that this natural lighting could also help to mitigate the detrimental effects of outdoor artificial lighting upon wildlife. Potential applications include use for ambient lighting, art installations, and indoor lamps.
To prevent pollution and the release of genetically modified organisms, the products would have to be collected for recycling and reuse so that the materials could be properly processed and made into new Life Bulbs.
The team won a gold medal when competing in the 2022 International Genetically Engineered Machine (iGEM) Competition, a global synthetic biology event held in Paris. The Life Bulb has since gone on to garner further accolades this year, including the top prize at the Okanagan Tech Industry Night in February and the Most Innovative Solution award at the iGEM Venture Creation Labs in April. The team is aiming to form a startup and commercialize the Life Bulb under a new name. This groundbreaking work is a significant step towards making eco-friendly lighting a living reality.
Fungus among us at home
Smart homes have become a reality. But what if our homes were alive, growing, and capable of producing food?
A multidisciplinary team from UBC is developing sustainable building materials made from edible fungi — think oyster, reishi, and turkey tail mushrooms. Combining their expertise in microbiology, biotechnology, engineering, and architecture, this team is crafting various materials made from mycelium, which is the root-like network of fungi.
As these organic building materials — ranging from bricks and blocks to insulation and gels — have low environmental impact, they could help reduce the environmental and energy demands of construction industries. As mycelium-based products are non-toxic, they could also be used as an alternative to foam insulation, which is potentially unhealthy and isn’t biodegradable. As an added bonus for home construction, research suggests that these materials can be fire-resistant.
Joseph Dahmen, an associate professor at the UBC School of Architecture and Landscape Architecture, is leading this inventive work. With over two decades of research into how low-carbon materials can be used in architecture, he founded the Biogenic Architecture Lab at UBC in 2021. The lab tackles environmental issues by designing architectural materials with living organisms. One of their notable projects is a living mycelium toilet that transforms human waste into soil, which will be piloted at the UBC Botanical Garden.
Companies have already used mycelium-based products to replace leather and plastic, including to eliminate packaging like Styrofoam or for use in apparel. Although mycelium bricks have been made before, the manufacturing process kills off the organisms. Dahmen and his team, in contrast, are exploring what happens if they’re kept alive and continue to grow. Perhaps in the near future, instead of going to the grocery store for mushrooms, we’ll simply harvest what sprouts up on the walls of our own home?

Eggs crack challenges in children’s cancer research
In the race against time to save children from cancer, something commonly found in the dairy section of supermarkets is breaking new ground.
Dr. James Lim (PhD’02), a UBC Faculty of Medicine’s Department of Pediatrics associate professor and a BC Children’s Hospital Research (BCCHR) Institute researcher, is pioneering a novel approach using chicken eggs to determine the most effective treatments for children’s cancer, especially those that are recurrent or resistant.
He and his colleagues are placing tumour cells from pediatric cancers into petri dishes containing chicken eggs to observe how they grow and respond to various medications. The team can then identify which drugs work best, why some fail, and determine which treatment is most effective. These elements help the researchers pinpoint the most successful treatments with the fewest side effects.
Although chicken eggs have been used in pre-clinical cancer research before, Lim is the first to use this model in pediatric cancer research. The rapidity of results is particularly advantageous.
“It takes just one to two weeks to grow a tumour from the time of the initial biopsy,” Lim says. “This represents a dramatic drop from the current standard of three to six months using other models.”
This innovative work is part of Better Responses through Avatars and Evidence (or BRAvE), which uses mass spectrometry and genome-sequencing technologies to determine the molecular makeup of childhood cancer tumours. This significant leap forward in the treatment of tumours offers a beacon of hope for children battling cancer.
Beyond butterflies in your stomach
Fried sakondry, a dish from Madagascar, uses bugs that taste like bacon. Beondegi is South Korean street food consisting of boiled or steamed silkworm pupae. Escamoles, or Mexican caviar, is made from ant larvae and pupae. Entomophagy, or eating insects as food, is acceptable in various regions or countries. In Canada and the United States? Not so much.
That’s changing. The global insect-protein market is forecast to skyrocket from its current value of hundreds of millions into billions by the end of the decade.
The consumption of insects as food can help tackle worldwide challenges. Nutritionally, insects are rich with protein, vitamins, calcium, and essential amino acids. Compared with traditional livestock, insect farming is more sustainable: it’s more economical; requires less land, water, and feed; and produces less greenhouse gases. Also, insects can be raised on food waste and their excrement can be used as fertilizer, thereby supporting the circular economy.
Such benefits are why UBC applied biology sessional lecturer Dr. Yasmin Akhtar (PhD’03) became interested in entomophagy and teaches the courses “Introduction to Entomology” (the study of insects) and “Insects as Food and Feed.”
“Insects can be a sustainable substitute to conventional meat sources to be able to feed the global population expected to reach more than nine billion by 2050,” she explains.
To overcome psychological barriers about eating insects, Akhtar has held the Great UBC Bug Bake Off five times to date. In the competition, judges (such as UBC executive chef David Speight) evaluate insect-based dishes made by teams of Faculty of Land and Food Systems students. Entries in the 2023 competition included mealworm ginger cookies, tacos with insect-based tortillas, and cranberry shortbread cookies with cricket flour. That edition also marked the first time that media were invited to attend, helping to boost public awareness about the value of insects as a food source.
Interested in integrating insects into your diet? Akhtar recommends barbecuing insects (purchased from insect farms) or using insect flour or powder as ingredients in recipes.
What does she think will help popularize devouring insects? Education and exposure.
“The more people consume it, the more it will be considered as a general food,” she says.
A version of this article was originally posted at the University of British Columbia Magazine and is reposted here with permission.

![]() | Videos | More... |

Video: Nuclear energy will destroy us? Global warming is an existential threat? Chemicals are massacring bees? Donate to the Green Industrial Complex!
![]() | Bees & Pollinators | More... |

GLP podcast: Science journalism is a mess. Here’s how to fix it

Mosquito massacre: Can we safely tackle malaria with a CRISPR gene drive?

Are we facing an ‘Insect Apocalypse’ caused by ‘intensive, industrial’ farming and agricultural chemicals? The media say yes; Science says ‘no’
![]() | Infographics | More... |

Infographic: Global regulatory and health research agencies on whether glyphosate causes cancer
![]() | GMO FAQs | More... |

Why is there controversy over GMO foods but not GMO drugs?

How are GMOs labeled around the world?

How does genetic engineering differ from conventional breeding?
![]() | GLP Profiles | More... |

Alex Jones: Right-wing conspiracy theorist stokes fear of GMOs, pesticides to sell ‘health supplements’








Viewpoint — Fact checking MAHA mythmakers: How wellness influencers and RFK, Jr. undermine American science and health
Viewpoint: Video — Big Solar is gobbling up productive agricultural land and hurting farmers yet providing little energy or sustainabilty gains
Fighting deforestation with CO2: Biotechnology breakthrough creates sustainable palm oil alternative for cosmetics
Trust issues: What happens when therapists use ChatGPT?
30-year-old tomato line shows genetic resistance to devastating virus
California, Washington, Oregon forge immunization alliance to safeguard vaccine access against federal undermining
The free-range chicken dilemma: Better for birds, but with substantial costs
‘You have to treat the brain first’: Rethinking chronic pain with Sanjay Gupta